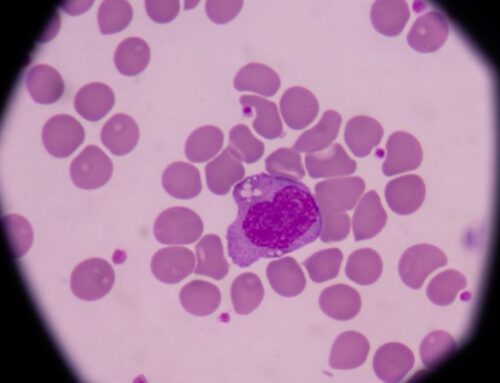
Eozinofilik gastrit teşhisi nasıl yapılır?

Eozinofilik gastrit tedavisi olarak uygulanan diyet tedavisinden çoğu hasta fayda görür. Amino Asit bazlı mamalar tercih edilmektedir. 1-2 hafta boyunda kortikosteroid tedavisi 0,5-1 mg/kg tedavi verilebilmektedir. Klinik olarak fayda sağlandıktan sonra oral yolla nebulize budesonid ve flutikazon propiyonat başlanabilmektedir.